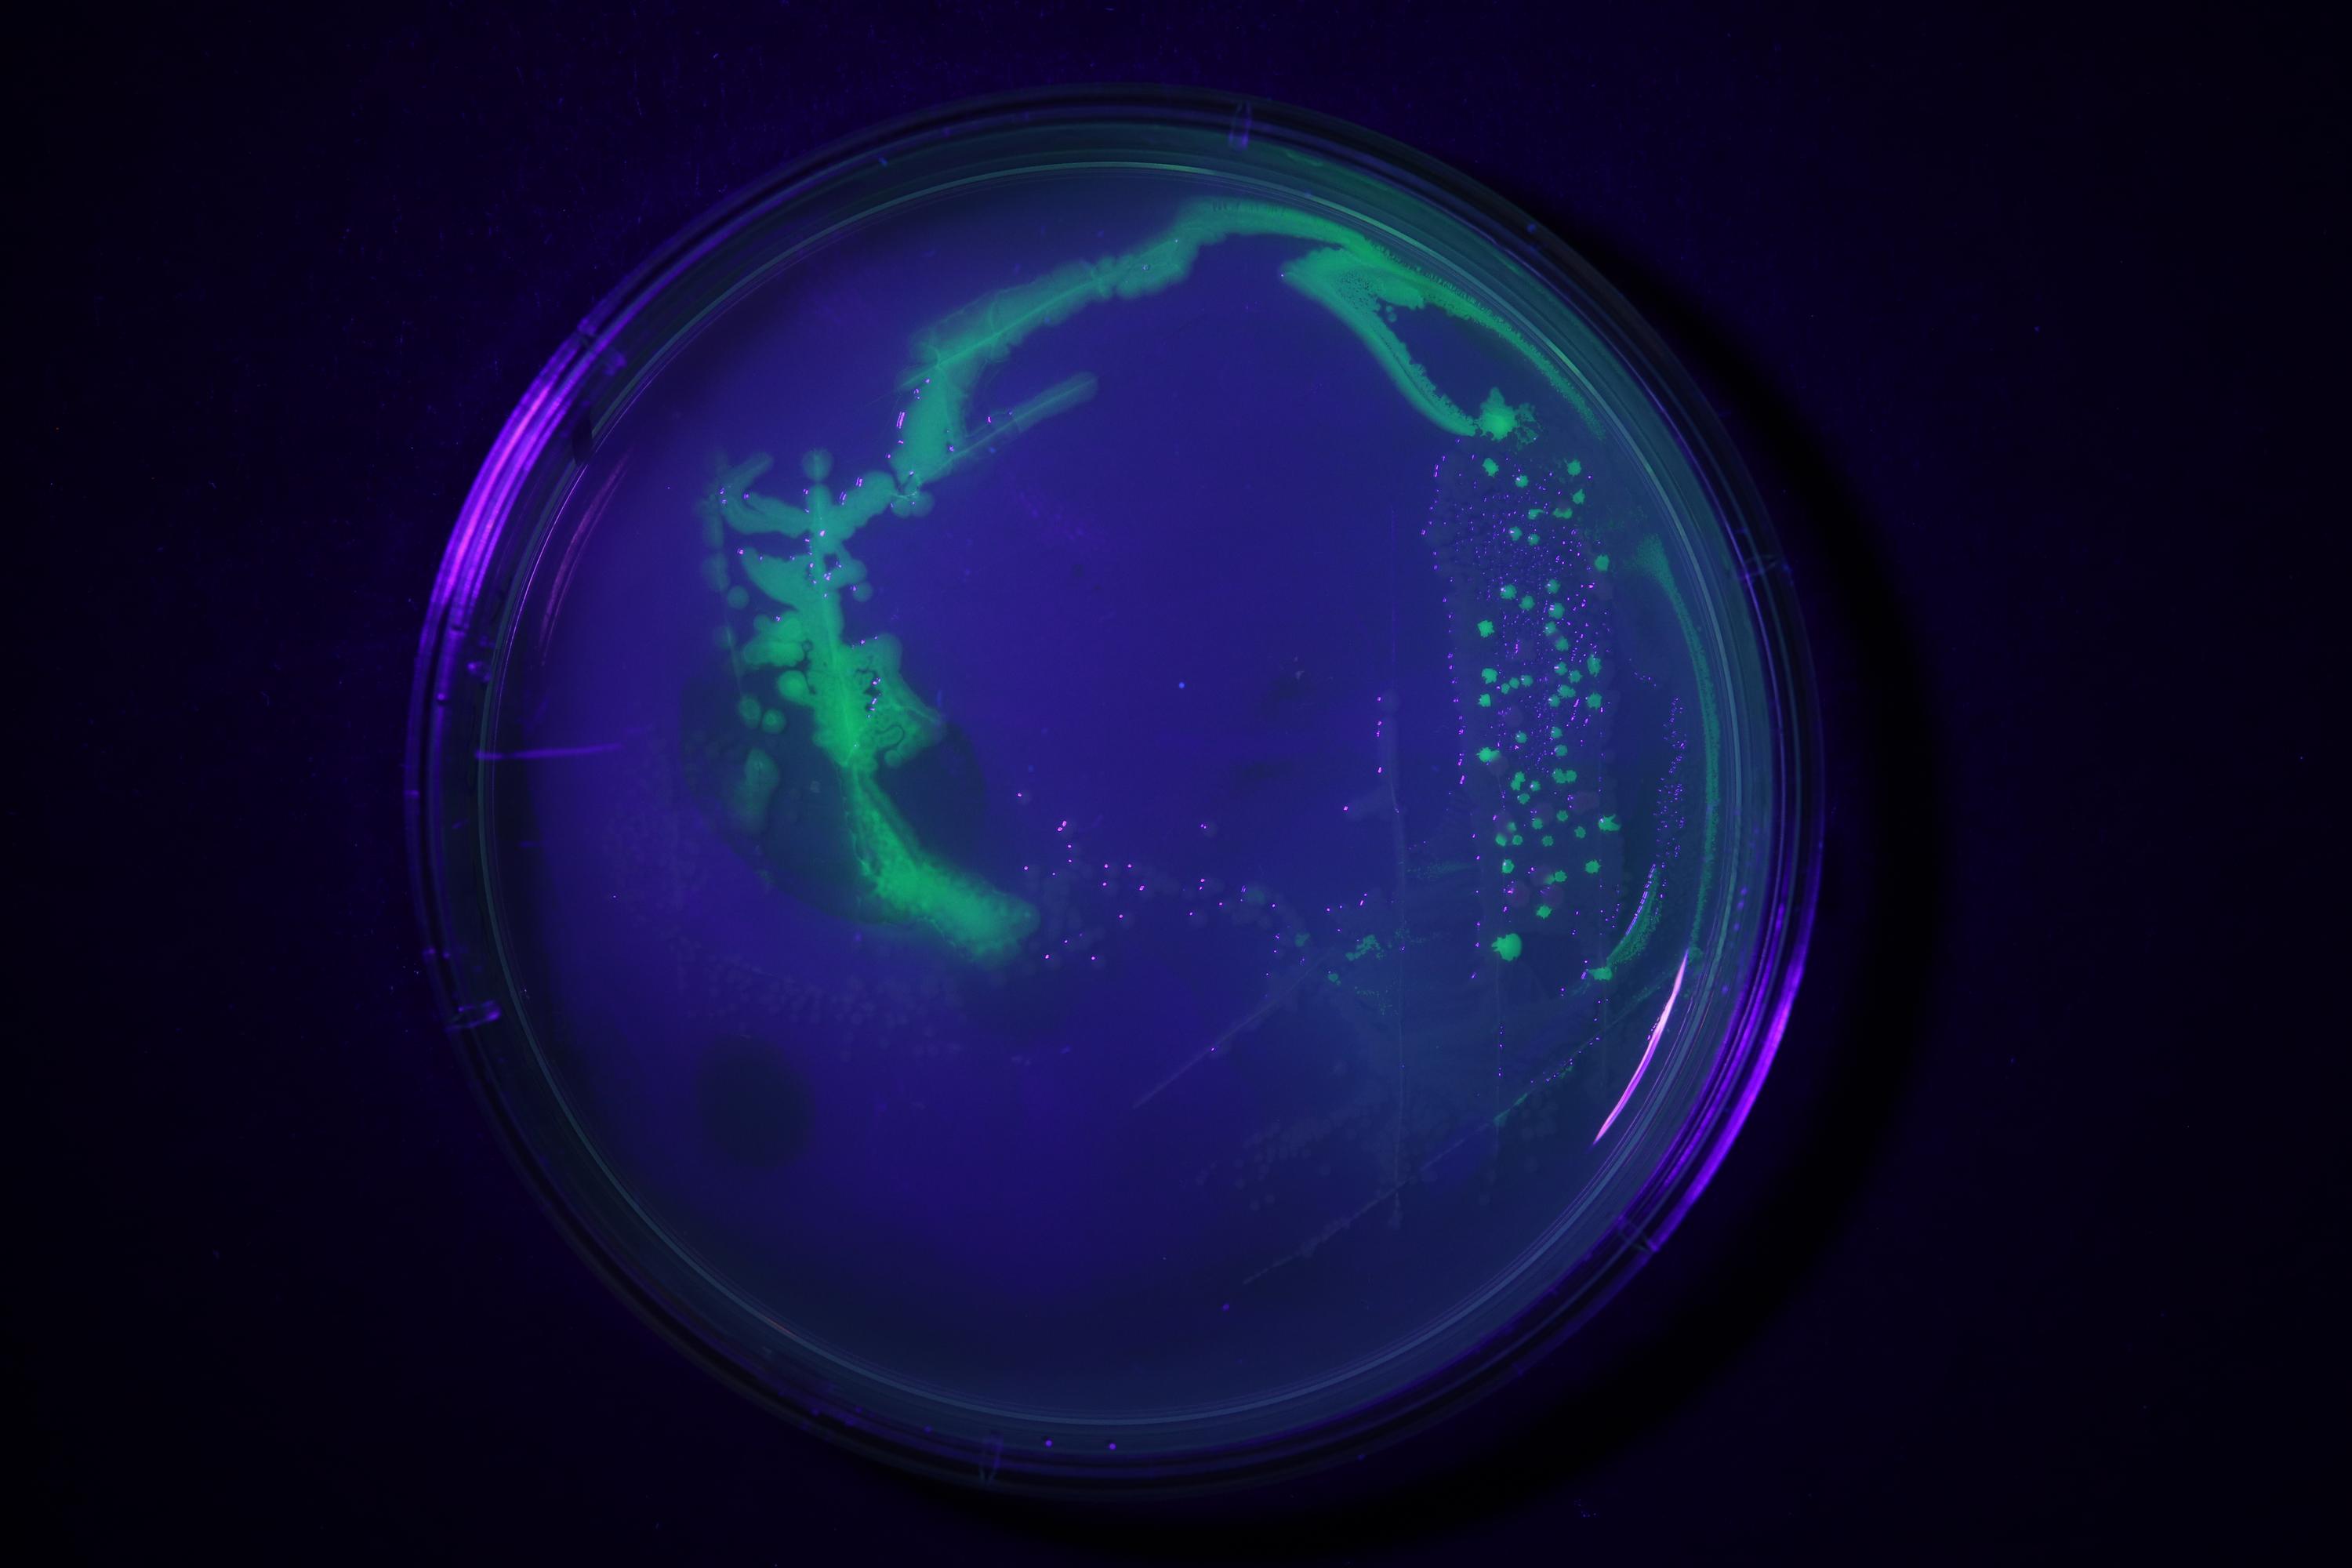

Lifefabs Institute x MIT Media Lab
‘How to Grow (Almost) Anything,’ is Harvard/MIT Media Lab’s synthetic biology course, to teach experienced bio-enthusiasts and those new to the life sciences alike skills at the cutting edge of bioengineering and synthetic biology.
With HTGAA democratising SynBio edcation through a distributed network of nodes - Lifefabs Institute is proud to be Europe’s node for HTGAA, allowing students to take part and running labs from our space.
Run by David Kong and George Church the course consists of three major modules: synthetic biology bootcamp, biofabrication and imaging and genome engineering. Each week features live lectures from experts in their respective domains and hands-on wet lab skills development hosted at Lifefabs Institute.
With HTGAA democratising SynBio edcation through a distributed network of nodes - Lifefabs Institute is proud to be Europe’s node for HTGAA, allowing students to take part and running labs from our space.
Run by David Kong and George Church the course consists of three major modules: synthetic biology bootcamp, biofabrication and imaging and genome engineering. Each week features live lectures from experts in their respective domains and hands-on wet lab skills development hosted at Lifefabs Institute.